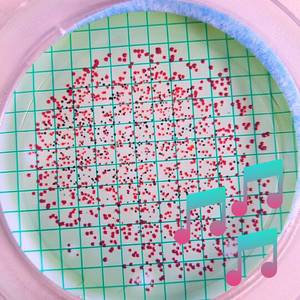
Australia Pharmacy

水の影
Aura Celebrations

水の影
藤原道山

水の音
りりィ

水の影
和紗

水の影
小野リサ

水の影
松任谷由実

水の影
松任谷由実

水の影
井上水晶

水の影(ボーナストラック|毎日放送連続テレビドラマ「幸福の断章」主題歌)
シモンズ

水の音
リラックスした音楽のアカデミー

水の影
松任谷由実

水の音
ランニングBGM

水の音
レイキヒーリングユニット

水の音
睡眠音楽の巨匠

水の音
白色雑音

水の音
Sleep Sounds of Nature

Autonomous Waves
水の音, Water Sounds

Stupendous Creator
水の音, Water Sounds

Revamp Silver
水の音, Water Sounds

Australia Pharmacy
水の音, Water Sounds

Revamp Silver
水の音, Water Sounds

Autonomous Waves
水の音, Water Sounds

Stupendous Creator
水の音, Water Sounds
Australia Pharmacy
水の音, Water Sounds

水の音
東洋音楽ゾーン

水の音
緩和領域

水の音
治療の音楽コレクション

水の音(瞑想)
癒し音マスター

水の音
Sleep Sounds of Nature

月の呪文
水の音, 白色雑音